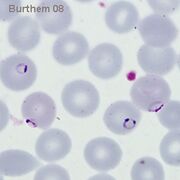
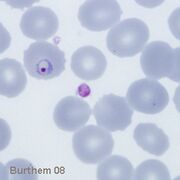
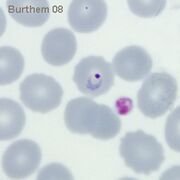
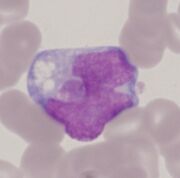

Uploads by John
This special page shows all uploaded files.
| Date | Name | Thumbnail | Size | Description | Versions |
|---|---|---|---|---|---|
| 10:48, 12 April 2024 | Malria blood stages.jpg (file) |  |
12 KB | 1 | |
| 15:44, 15 March 2024 | Double4.jpg (file) |  |
25 KB | 1 | |
| 15:43, 15 March 2024 | Double3.jpg (file) |  |
28 KB | 1 | |
| 15:43, 15 March 2024 | 11double3.jpg (file) |  |
28 KB | 1 | |
| 15:42, 15 March 2024 | Double2.jpg (file) |  |
35 KB | 1 | |
| 15:36, 15 March 2024 | Double1.jpg (file) |  |
30 KB | 1 | |
| 15:41, 5 March 2024 | PFET5p.jpg (file) |  |
68 KB | 1 | |
| 13:45, 5 March 2024 | PFET4p.jpg (file) |  |
87 KB | 1 | |
| 13:38, 5 March 2024 | PFET3p.jpg (file) |  |
83 KB | 1 | |
| 13:53, 2 March 2024 | PFET2p.jpg (file) |  |
55 KB | 2 | |
| 13:38, 2 March 2024 | PFET1p.jpg (file) |  |
55 KB | 1 | |
| 12:27, 26 February 2024 | PFETi6.jpg (file) | |
38 KB | 1 | |
| 12:22, 26 February 2024 | PFETi5.jpg (file) |  |
37 KB | 1 | |
| 12:21, 26 February 2024 | PFETi4.jpg (file) | |
36 KB | 1 | |
| 12:13, 26 February 2024 | PFETi3.jpg (file) |  |
36 KB | 1 | |
| 12:12, 26 February 2024 | PFETi2.jpg (file) |  |
35 KB | 1 | |
| 12:12, 26 February 2024 | PFETi1.jpg (file) | |
35 KB | 1 | |
| 18:35, 22 February 2024 | PKSc.jpg (file) |  |
41 KB | 1 | |
| 18:35, 22 February 2024 | PKGc.jpg (file) |  |
49 KB | 1 | |
| 18:35, 22 February 2024 | PKLTc.jpg (file) |  |
50 KB | 1 | |
| 18:34, 22 February 2024 | PKETc.jpg (file) |  |
41 KB | 1 | |
| 23:58, 21 February 2024 | PMSc.jpg (file) |  |
57 KB | 1 | |
| 23:55, 21 February 2024 | PMGc.jpg (file) |  |
77 KB | 1 | |
| 23:55, 21 February 2024 | PMLTc.jpg (file) |  |
55 KB | 1 | |
| 23:54, 21 February 2024 | PMETc.jpg (file) |  |
62 KB | 1 | |
| 23:41, 21 February 2024 | POGc.gif (file) |  |
116 KB | 1 | |
| 23:41, 21 February 2024 | POSc.jpg (file) |  |
69 KB | 1 | |
| 23:40, 21 February 2024 | POLTc.jpg (file) |  |
68 KB | 1 | |
| 23:40, 21 February 2024 | POETc.jpg (file) |  |
58 KB | 1 | |
| 20:03, 21 February 2024 | FVETc.jpg (file) |  |
67 KB | 1 | |
| 20:00, 21 February 2024 | PVGc.jpg (file) |  |
69 KB | 1 | |
| 19:59, 21 February 2024 | PVSc.jpg (file) |  |
68 KB | 1 | |
| 19:59, 21 February 2024 | PVLTc.jpg (file) |  |
66 KB | 1 | |
| 19:47, 21 February 2024 | PFETc.jpg (file) |  |
197 KB | 2 | |
| 19:42, 21 February 2024 | PFGc.jpg (file) |  |
47 KB | 1 | |
| 19:42, 21 February 2024 | PFLTc.jpg (file) |  |
42 KB | 1 | |
| 17:48, 5 January 2024 | Lymphoblast.png (file) |  |
153 KB | 1 | |
| 12:24, 15 December 2023 | AMLM5B.jpg (file) | |
32 KB | 1 | |
| 12:24, 15 December 2023 | AMLM5A.jpg (file) |  |
31 KB | 1 | |
| 11:06, 18 October 2023 | AML M2.png (file) |  |
146 KB | 1 | |
| 11:03, 18 October 2023 | AML M1.png (file) |  |
174 KB | 1 | |
| 16:58, 13 July 2023 | CD45-PopA.jpg (file) |  |
29 KB | 2 | |
| 14:49, 13 July 2023 | DLBCL.jpg (file) |  |
41 KB | 1 | |
| 10:27, 13 July 2023 | CD45 populations.jpg (file) |  |
59 KB | 1 | |
| 10:23, 13 July 2023 | CD45-PopE.jpg (file) |  |
49 KB | 1 | |
| 10:22, 13 July 2023 | CD45-PopD.jpg (file) |  |
36 KB | 1 | |
| 10:22, 13 July 2023 | CD45-PopC.jpg (file) |  |
39 KB | 1 | |
| 10:21, 13 July 2023 | CD45-PopB.jpg (file) |  |
42 KB | 1 | |
| 10:14, 13 July 2023 | CD45-PopB.png (file) |  |
233 KB | 1 | |
| 10:10, 13 July 2023 | CD45 populations.png (file) |  |
427 KB | 1 |